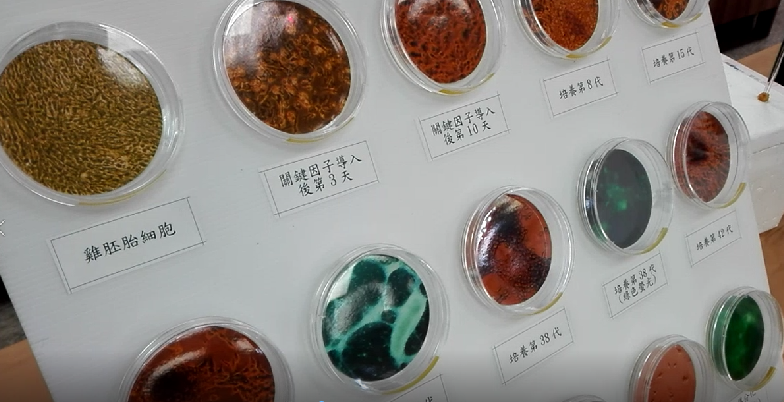

【台灣醒報記者譚有勝台北報導】首個MIT(Made in Taiwan)家禽幹細胞株研發成功!畜產試驗所副研究員劉振發14日受訪時表示,「胚胎蛋若培育40天後會死掉,但幹細胞株卻能持續培育400天,有利台灣進行更多生醫研究,包括鳥類保種,疫苗生產研究等。」他也說,幹細胞株生產疫苗風險低,可避免民眾用藥時,對雞蛋過敏產生排斥的問題。
為了提供穩定的幹細胞株供生醫研究使用,畜產試驗所開發出台灣首個「雞誘導多能性幹細胞株」。雖然家禽常被使用在疫苗開發的研究,但能夠供研究使用的幹細胞株卻非常少。因此,我國許多的疫苗生產研究都是利用活化風險性較高的「胚胎蛋」進行生產,導致疫苗生產過程時常短缺。
畜產試驗所副研究員劉振發14日受訪時表示,「胚胎蛋若在40天後會死掉,但是導入這個技術後,能夠將幹細胞維持400天持續培育。」早期幹細胞的培養是從老鼠來的,但家禽的幹細胞比較少,這個技術的關鍵成就在於有利做其他生醫研究,包括鳥類保種、疫苗生產研究等。
劉振發進一步說,疫苗生產多數都是用胚胎蛋研發,但是胚胎蛋的活化性太弱,唯有將這種幹細胞取代它,才能夠讓疫苗生產更為穩定。他強調,這種穩定性高的幹細胞不但能夠讓疫苗研究更為順利,也可以避免讓對雞蛋過敏的民眾產生排斥的問題。

